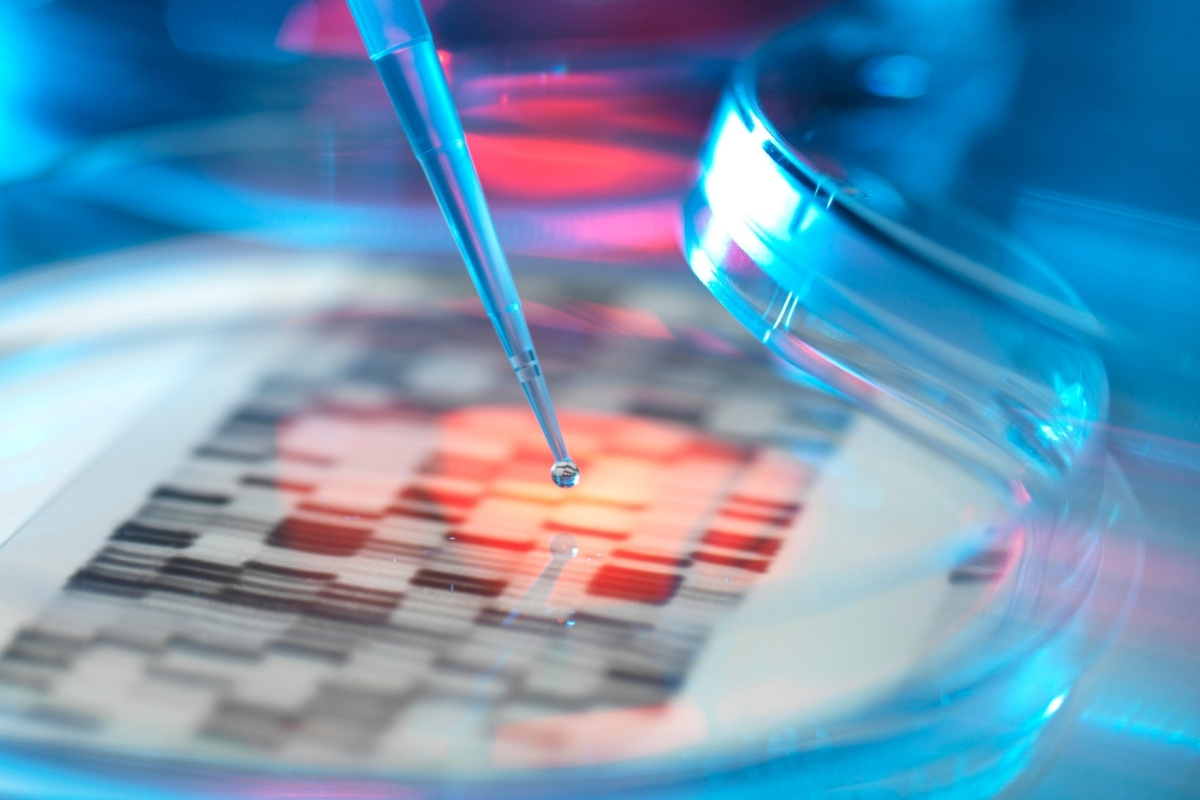
test WGS

Uncategorized
Ce spun genele tale despre tine? 5 lucruri esențiale despre testarea genetică (testul WGS)
E incredibil cât de mult a evoluat știința în ultimii ani. Testarea genetică nu mai e un concept futurist, ci a devenit un instrument puternic care ne ajută să înțelegem mai bine cine suntem și ce ne face unici. Gândește-te la tehnologii ca secvențierea întregului genom (test WGS), care a transformat felul în care medicii pun un diagnostic, previn bolile și personalizează tratamentele.
Dacă ești curios să afli ce se ascunde în spatele acestor teste, cum funcționează și ce pot face ele pentru tine, am pregătit o listă cu 5 lucruri esențiale pe care ar trebui să le știi.
1. WGS îți arată întreaga „hartă” genetică
Secvențierea întregului genom (WGS) este ca o radiografie a ADN-ului tău. În loc să scaneze doar anumite zone, WGS citește fiecare detaliu din cei aproximativ 3 miliarde de „pași” care formează genomul uman. Asta înseamnă că nu se limitează doar la genele care produc proteine, ci analizează și acele regiuni despre care nu știam prea multe, dar care se pare că au un rol important în felul în care funcționează corpul nostru.
2. E un instrument de ultimă instanță
Testul WGS este, de obicei, recomandat atunci când celelalte teste genetice nu au reușit să ofere un răspuns. Să zicem că ai o boală rară și medicii au epuizat toate celelalte variante. În aceste cazuri, WGS poate oferi acel indiciu crucial, fie că vorbim de boli neurologice ca autismul, de malformații congenitale sau chiar de bolile mitocondriale.
De asemenea, testul WGS joacă un rol vital în lupta cu cancerul, ajutând medicii să descopere mutațiile care stau la baza unei tumori sau să identifice riscul de a dezvolta un cancer ereditar. Nu în ultimul rând, este folosit în medicina reproductivă, pentru a ajuta cuplurile să înțeleagă riscul de a transmite anumite boli genetice copiilor lor.
3. Nu este pentru oricine și are și limitele sale
Deși testul WGS sună ca un panaceu, are și limitări. Nu este recomandat oricui și în orice situație. Un medic genetician va discuta cu tine riscurile și beneficiile. Un aspect crucial este consimțământul informat, care se asigură că înțelegi pe deplin ce implică testul.
O altă provocare majoră este interpretarea rezultatelor. Uneori, testul găsește variante cu semnificație incertă (VUS), adică schimbări în ADN despre care oamenii de știință nu știu încă ce înseamnă. Asta poate crea confuzie și anxietate. Aici, rolul unui consilier genetician devine important, pentru a te ajuta să înțelegi corect informațiile și să te pregătești pentru posibilele riscuri emoționale.
4. Mai mult decât un diagnostic, este un ghid pentru viitor
Unul dintre cele mai mari avantaje ale WGS este că oferă o bază solidă pentru medicina personalizată. Cunoscând profilul tău genetic, medicii pot alege tratamente mult mai eficiente, adaptate nevoilor tale. Datele obținute în urma unei secvențieri pot fi reanalizate în viitor, pe măsură ce apar noi descoperiri medicale.
5. Contribuie la viitorul medicinei și al cercetării
Nu în ultimul rând, informațiile colectate prin testul WGS sunt o resursă neprețuită pentru cercetarea științifică. Ele ne ajută să înțelegem mai bine evoluția, diversitatea populațiilor și, cel mai important, contribuie la dezvoltarea de noi tratamente și terapii inovatoare.
În concluzie, testarea genetică este un domeniu complex și în continuă evoluție. Fiecare metodă are specificul ei, iar alegerea celei potrivite depinde de situația ta. Cel mai important este să ții minte că rezultatele trebuie interpretate de specialiști și că sprijinul unui consilier genetician este vital pentru a înțelege pe deplin toate implicațiile informațiilor obținute.
Dacă te gândești să faci o astfel de analiză, CentruGenetica.ro te poate ghida prin toate etapele, oferindu-ți sprijinul și expertiza de care ai nevoie pentru a lua decizii informate.
Uncategorized
Grupul SGS își consolidează oferta de servicii de Încredere Digitală prin lansarea unui cadru global structurat

Geneva, 29 October 2025 –
Grupul SGS, lider mondial in domeniul testarii, inspectiei si certificarii, anunta noul cadru global care reuneste intr-o abordare coerenta si bine structurata serviciile dedicate Increderii Digitale – SGS DIGITAL TRUST: Across technologies, services and organizations
Bazat pe expertiza noastră globală recunoscută, acest cadru diversifică și consolidează soluțiile oferite, sprijinind organizațiile să navigheze în siguranță prin peisajul complex al Încrederii Digitale.
Încrederea digitală reprezintă de mult timp o prioritate strategică pentru Grupul SGS, fiind definită ca pilon esențial al Strategy 27: Accelerarea creșterii, consolidarea încrederii, prezentată în cadrul Capital Markets Event 2024. Lansarea SGS DIGITAL TRUST, care coincide cu Luna conștientizării securității cibernetice, marchează o nouă etapă în sprijinul acordat organizațiilor pentru gestionarea riscurilor digitale contemporane.
De la inteligență artificială și tehnologii conectate până la infrastructuri complexe, acest cadru integrează serviciile noastre într-un mod clar și unitar, oferind clienților posibilitatea de a construi, demonstra și menține încrederea în întregul ecosistem digital.
La baza sa se află patru piloni strategici care acoperă toate dimensiunile Încrederii Digitale:
- Produse și tehnologii conectate
- Servicii și infrastructură digitală
- Date și inteligență artificială
- Organizații și oameni
Acest cadru abordează aspectele esențiale ale încrederii: siguranță, securitate cibernetică, confidențialitate, echitate, transparență și sustenabilitate. El sprijină industrii precum infrastructura critică, tehnologia medicală, mobilitatea, electronica de consum și tehnologia wireless, dar și domenii precum plățile, identitatea digitală, telecomunicațiile, spațiul și semiconductorii.
Indiferent că vorbim despre planificare sigură, audituri de conformitate, evaluări tehnice, testare sau monitorizare continuă, SGS rămâne partenerul de încredere pentru construirea și menținerea Încrederii Digitale.
Géraldine Picaud, CEO SGS, a declarat: „Ca parte a Strategy 27, Încrederea Digitală reprezintă un pilon cheie de creștere pentru SGS. Noul cadru duce expertiza noastră la un nivel superior, consolidându-ne rolul de partener independent în ecosistemul digital.”
Aflați mai multe la sgs.com/digital-trust.
Uncategorized
Training de top pentru tehnicieni frigotehniști: DAAS Epta România lansează centrul din Ploiești

Investiție de peste 500.000 de euro în educație și tehnologie: mediul privat preia inițiativa formării tehnicienilor, după modelul centrelor din Germania și Italia.
DAAS Epta România, parte a grupului internațional Epta, anunță inaugurarea oficială a primului Training Center dedicat tehnicienilor frigotehniști din România și debutul primei serii de cursanți. Cu o investiție de peste 500.000 de euro, proiectul marchează o premieră pentru industria de refrigerare locală și poziționează România ca hub regional de excelență în formarea specialiștilor.
DAAS Epta Training Center (DETC), situat în incinta sediului din Ploiești, reprezintă o inițiativă unică în mediul privat, dezvoltată după modelul academiilor Epta din Germania și Italia. Centrul răspunde unei nevoi critice de formare în sectorul instalațiilor frigorifice – un domeniu-cheie pentru retail, logistică și industria alimentară – și oferă cursuri practice și teoretice pe patru niveluri, de la începător la specialist, integrând atât competențe tehnice, cât și sesiuni de soft skills susținute cu sprijinul echipei de Resurse Umane.
Cursurile sunt hands-on, bazate pe echipamente de ultimă generație: instalații frigorifice funcționale cu agenți naturali, panouri electrice, pompe de căldură și vitrine „best in class” dezvoltate de Epta. Infrastructura centrului include un showroom dedicat tehnologiei Epta, o sală de training pentru ucenici unde se învață bazele refrigerării și săli de studiu teoretic moderne și complet echipate. Tehnologiile emergente, precum realitatea virtuală și inteligența artificială, vor fi integrate treptat în sesiunile de formare, oferind un mediu educațional complet și relevant pentru cerințele actuale ale industriei.

Prima serie de cursanți și conceptul de formare
Prima serie este formată din angajați ai companiei DAAS, provenind din diverse departamente — telemonitorizare, service, montaj — și are rolul de a optimiza conținutul viitoarelor programe. Cursurile sunt predate de formatori interni cu experiență extinsă în domeniu, absolvenți ai programelor de certificare pentru formatori.
Fiecare zi de curs include sesiuni teoretice, practice și de soft skills, iar participanții sunt evaluați prin teste zilnice și evaluări săptămânale. În timpul sesiunilor practice se folosesc echipamente de ultimă generație: instalații frigorifice cu agenți naturali, centrale dotate cu sisteme ETE și FTE, soluții digitale de tip LineON și SwitchON, precum și platformele de telemonitorizare cele mai utilizate în industrie.
Centrul are o capacitate de 20–30 de participanți, dar se concentrează pe grupe restrânse de maximum 8 cursanți, pentru a asigura o formare reală și individualizată. Durata unui curs este de o săptămână pentru fiecare nivel, iar după perioada de practică pe teren, cursanții pot accesa nivelul următor pe baza unui test de evaluare. În prima etapă, toți cei peste 230 de angajați DAAS Epta România vor urma programele de training, urmând ca ulterior centrul să se deschidă și către elevi, studenți și parteneri din industrie.

Educație aplicată și parteneriate strategice
DAAS colaborează cu Liceul „Elie Radu” din Ploiești, universități tehnice și cu Asociația Frigotehniștilor din România, pentru a atrage tineri către o carieră tehnică stabilă și modernă. În paralel, compania derulează programe de tip „porți deschise” și intenționează să obțină acreditare pentru emiterea certificărilor oficiale de frigotehnist.
„Prin acest centru, mediul privat face un pas concret în direcția formării profesionale — acolo unde sistemul public are încă un deficit major. Prima serie este doar începutul: ne dorim să construim o generație de specialiști în refrigerare, bine pregătiți tehnic și conectați la realitatea digitală a industriei. Investim în oameni, pentru că doar așa putem susține performanța și inovația pe termen lung”, declară Daniel Mocanu, Director General DAAS Epta România.

România – centru regional de excelență pentru Epta Group
Odată cu deschiderea Training Center-ului, DAAS Epta România își consolidează statutul de centru regional de excelență pentru servicii de telemonitorizare (TLM), cu obiectivul de a gestiona peste 3.000 de locații monitorizate până la finalul anului 2025, atât în România, cât și pe piețele internaționale.
Epta Group – lider global în refrigerare
Epta Group, lider european și al doilea la nivel mondial în refrigerare comercială, investește masiv în dezvoltare, cercetare și digitalizare. O mare parte din tehnologia de top a grupului este disponibilă în acest Training Center, oferind cursanților oportunitatea de a învăța într-un mediu care le garantează succesul.
Despre DAAS Epta România
Fondată în 1993, DAAS Epta România este lider în soluții integrate de refrigerare comercială, HVAC și food service. Cu o experiență de peste 30 de ani, compania oferă servicii de inginerie, mentenanță și project management pentru retail, logistică și HoReCa. Din 2015, face parte din Epta Group, jucător global cu o cifră de afaceri de 1,7 miliarde de euro și operațiuni în peste 80 de țări.
Uncategorized
ELKO Romania adaugă brandul ONKRON în portofoliu – soluții profesionale pentru montarea și suportul echipamentelor video și IT

București, 28 October 2025 – ELKO Romania, parte a ELKO Group, unul dintre cei mai mari distribuitori de produse, soluții IT și electronice de consum din regiune, anunță extinderea portofoliului său prin includerea brandului ONKRON, producător global de suporturi TV profesionale, sisteme reglabile pentru monitoare și videoproiectoare, standuri mobile și soluții VESA universale.
Prin acest parteneriat, ELKO Romania își consolidează oferta de produse destinate mediilor corporate, educaționale și rezidențiale, oferind partenerilor și clienților soluții flexibile, fiabile și ușor de integrat pentru gestionarea echipamentelor video și de afișaj.

“Am observat din cererea partenerilor noștri o nevoie tot mai mare pentru soluții de mounting, corelat cu creșterea pe care o vedem în zona de digital signage. Prin extinderea portofoliului nostru, putem oferi acum o soluție completă pentru parteneri”, a declarat Marius-Beniamin Dumitrașcu, Product Manager @ELKO.
Portofoliul inițial include produse concepute pentru a răspunde cerințelor spațiilor moderne – de la birouri și săli de conferință, până la showroom-uri, spitale sau instituții de învățământ.
Adăugarea brandului ONKRON în portofoliul ELKO Romania completează direcția strategică a companiei de a livra soluții complete și moderne pentru orice tip de mediu tehnologic. Produsele ONKRON se remarcă prin versatilitate, design ergonomic și o calitate excelentă a fabricației – valori care se aliniază filozofiei de distribuție a ELKO Romania.

Produsele ONKRON vin să răspundă unei cereri tot mai mari pe piața românească, unde integrările audio-video, digital signage-ul, sălile de conferință, zonele comerciale și spațiile educaționale impun soluții profesionale, sigure și compatibile universal. Gama ONKRON acoperă diagonale variate – de la televizoare și monitoare standard până la panouri mari de până la 120” – oferind funcționalități avansate de montare (înclinare, rotație, braț extensibil, profil redus) și o instalare rapidă și sigură. Prin aceste caracteristici, ONKRON completează perfect portofoliul ELKO Romania și răspunde nevoilor tot mai complexe ale partenerilor și integratorilor din domeniu.

Cu o prezență globală și un portofoliu extins, ONKRON s-a impus ca unul dintre principalii producători de soluții de montare și mobilitate pentru ecrane, monitoare și videoproiectoare, oferind compatibilitate universală, stabilitate ridicată și un nivel înalt de siguranță în utilizare.
Mai multe informații despre produsele ONKRON sunt disponibile pe site-ul oficial: www.onkron.com.
Despre ELKO Group și ELKO Romania
ELKO Group este unul dintre cei mai mari distribuitori de produse, soluții IT și electronice de consum din regiune, reprezentând peste 350 de producători. Cu o experiență de peste 30 de ani, compania oferă o gamă largă de produse și servicii către mai mult de 10.000 de retaileri, producători de calculatoare, integratori de sisteme și companii din diferite domenii, în 13 țări din Europa și Asia Centrală. Cifra de afaceri a ELKO Group în 2024 s-a ridicat la 1.143 mil. USD (1.056 mil. EUR), cu o rată de profitabilitate brută de 7.8%. Aflați mai multe informații de pe site: www.elkogroup.com
ELKO Romania face parte din Grupul ELKO și este specializată în distribuția unei game extinse de echipamente și soluții IT. Portofoliul său include PC-uri, componente hardware, electronice pentru uz casnic și de birou, telefoane mobile, software, infrastructură IT și soluții de stocare, soluții de securitate, echipamente industriale, sisteme de comunicații, precum și electronice de consum. ELKO Romania comercializează aceste produse exclusiv prin intermediul partenerilor săi: reselleri, retaileri, magazine online, companii specilalizate în proiectarea, instalarea și distribuția de soluții IT, sisteme de comunicații și de supraveghere video. Această abordare permite ELKO Romania să acopere toate canalele de distribuție IT & Telecom și să ofere soluții complete și adaptate pentru diversele nevoi ale clienților săi. Mai multe informații la: www.elko.ro
-

 Socialacum 2 luni
Socialacum 2 luniAlexandru Ferariu – antreprenorul român care își construiește discret imperiul în România și Republica Moldova
-

 Uncategorizedacum o lună
Uncategorizedacum o lunăPrimul tratament oral pentru diabet cu beneficii asupra inimii, aprobat în Europa
-

 Uncategorizedacum 2 luni
Uncategorizedacum 2 luniCasa Artelor din Sibiu – șansa unică a României de a câștiga Premiul Publicului Europa Nostra 2025
-

 Afaceriacum o lună
Afaceriacum o lunăCum facem drenajul corect al fosei septice: ghid complet pentru o funcționare optima
-

 Afaceriacum o lună
Afaceriacum o lunăCămin de bătrâni modern în București – „Acasă la bunici”
-

 Afaceriacum o lună
Afaceriacum o lunăStartul sezonului de toamnă la solarii: cum își pregătesc fermierii culturile pentru iarnă și primăvară
-

 Afaceriacum o lună
Afaceriacum o lunăRochițe elegante de zi: 5 modele care te fac și mai frumoasă la evenimente
-

 Uncategorizedacum o lună
Uncategorizedacum o lunăAndrew Melchior aduce experiența din spatele Massive Attack și Björk la Festivalul de Transfer Tehnologic, TECHConnect – înscrieri încă deschise





















